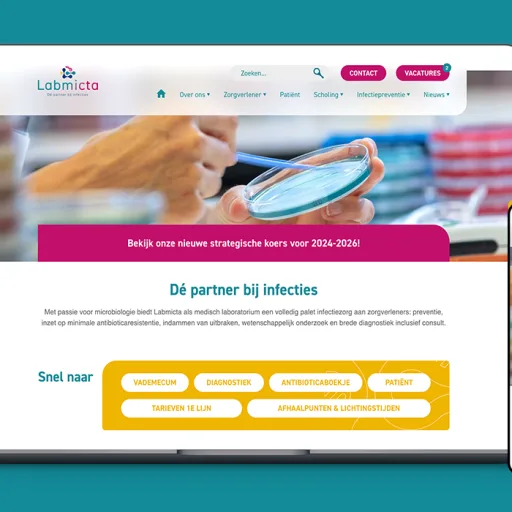

Het belang van UX Design
UX design is cruciaal tijdens de ontwikkeling van een product. Een goede UX kan het verschil maken tussen tevreden klanten en gefrustreerde gebruikers. Vraag jezelf eens af: hoe gebruiksvriendelijk is jouw product? Is er na de lancering nog iets mee gedaan? Biedt het product een intuïtieve, efficiënte en relevante ervaring aan de gebruiker? Standout helpt je om continu te optimaliseren. Wij ontwerpen structuren die gebruiksvriendelijk zijn en waarde leveren voor de gebruiker.
Naast tevreden gebruikers kunnen ook de bedrijfsresultaten verbeteren door goede UX. Met hogere conversie, meer klantloyaliteit en een betere reputatie. Of het helpt om supportkosten te verlagen, doordat gebruikers minder problemen ondervinden en gemakkelijker hun weg vinden in het product.
Het verschil tussen User Experience (UX) Design en User Interface (UI) Design
Bij User Experience Design draait het om de functies en een optimale gebruikersreis. User Interface Design focust zich daarentegen op het uiterlijk en de vormgeving. Een UI Designer doet in principe het digitale grafische ontwerp. Denk hierbij aan het toepassen van de branding en de animaties van de interacties. Het gaat hierbij dus om de presentatie en de visuele aantrekkingskracht van het product.